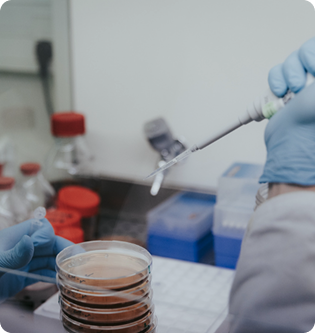

Avec plus de 20 années d’expertise en microbiologie, immunologie, génie génétique et IA, faisant de nous un acteur incontournable dans la recherche et l’innovation autour du microbiome
Nous réalisons des tests et analyses complexes, sur-mesure et scientifiquement robustes, pour vous accompagner dans vos développements les plus innovants

Porté par la Cosmetic Valley, ce groupe réunit experts, marques, fournisseurs d’ingrédients et laboratoires pour définir les bonnes pratiques de tests microbiome
Marques et fabricants d’ingrédients
Laboratoires et fabricants pharmaceutiques
Marques et fabricants de produits pour animaux

Notre savoir-faire se déploie dans de multiples typologies de produits conçus par nos clients.
Équilibre cutané
Diversité du microbiome
Réduction dermatite atopique
Boost de l’activité prebiotique
Effet anti-acne
...
Prévention de la prolifération de bactéries cariogéniques
Préservation des bactéries orales
Activité anti-bactérienne
Action anti mauvaise-haleine
...
Action anti-pelliculaire
Équilibre du cuir chevelu
...
Traitement des infections vaginales
Ré-équilibre du microbiome vaginal
Respect de la flore vaginale
...

De la validation de vos formulations à leur valorisation marketing, nous vous aidons à faire de la science un véritable atout concurrentiel.


Un article très complet sur BYOME DERMA et notre récente levée de fond.

Apprenez en plus sur : le rôle du microbiome dans la personnalisation des soins, notre approche Microbiome Respect, et le lancement de BYOME DERMA pour mieux relier profils de peau et produit.

Ils nous font confiance : Remora Biotech, Paris Business Angels et Angels Santé accompagnent l’essor de BYOME DERMA. Découvrez pourquoi dans cet article Le Point.
Notre test rapide d'analyse du microbiome
Étudiez l'impact de votre produit sur le microbiome
Pour des produits respectueux du microbiome
17 experts en microbiologieUne équipe pour vous accompagner dans vos projets
De nombreux business cases clients sur les microbiomes du skin, scalp, buccal et vaginal

5000 séquençages étudiés

Une maîtrise du microbiome sous forme planctonique et biofilm, la forme de vie naturelle des bactéries
20 années d'expertise sur le microbiome


Une souchothèque large et maitrisée en biofilm et planctonique y compris sur des souches telles les Malassezia
Plus de 250 publications Et études cliniques analysées



Vos questions sur nos prestations
Non, chez BYOME LABS nous travaillons sur les microbiomes cutanés mais aussi du cuir chevelu, oral et vaginal. Notre expertise scientifique nous permet de comprendre et d’analyser précisément les interactions entre les produits cosmétiques et ces écosystèmes délicats, garantissant des résultats fiables et pertinents pour vos formulations.
Les tests in vivo sont réalisés directement sur des volontaires humains, tandis que les tests in vitro sont effectués en laboratoire sur des échantillons biologiques ou des cultures de cellules. Chez Byome Labs, nous privilégions les tests in vitro pour leur précision et leur reproductibilité, tout en permettant de contrôler strictement les conditions expérimentales. Cette approche offre des résultats fiables tout en évitant les variations dues aux différences individuelles de chaque personne.
Nos choix de souches sont guidés par leur pertinence et leur représentativité dans le microbiome cutané humain. Nous sélectionnons les souches qui ont une influence majeure sur la santé de la peau, qu’il s’agisse de souches couramment présentes ou de celles impliquées dans des déséquilibres cutanés, afin d’assurer des résultats scientifiques les plus significatifs pour vos produits.
Nous travaillons avec les deux types de souches : les souches de référence, qui sont bien caractérisées et largement utilisées dans les études scientifiques, ainsi que les souches sauvages, directement issues du microbiome naturel. Cette double approche nous permet de fournir des résultats qui reflètent la diversité et la complexité réelle du microbiome cutané.
Vous pouvez compter environ un mois entre la réception de votre produit dans notre laboratoire de Clermont-Ferrand et la mise à disposition de votre rapport complet avec tous les résultats. Ce délai inclut toutes les étapes nécessaires pour garantir des analyses précises et rigoureuses.
Les tarifs pour nos prestations sont les suivants :
3 900 euros pour le test en mode planctonique.
6 300 euros pour le test en mode biofilm.
Ces coûts incluent une analyse complète ainsi qu’un rapport détaillé qui vous permettra de valoriser vos allégations marketing et d’assurer la transparence envers vos consommateurs.
Ne manque rien et suivez toute l’actualité de BYOMELABS en vous inscrivant à notre newsletter.
Vous désirez prendre rendez-vous ou souhaitez plus d’informations ?
Vous pouvez nous joindre en remplissant le formulaire de contact ci-contre ou par mail à : info@byome-labs.v-labs.fr
BYOME LABS
Cité de l’Innovation
7 rue Auguste Rodin
28630 LE COUDRAY
This site is protected by reCAPTCHA and the Google Privacy Policy and Terms of Service apply.
Notre site utilise des cookies pour améliorer votre expérience de navigation. En continuant à utiliser notre site, vous acceptez notre utilisation de cookies conformément à notre politique de confidentialité.